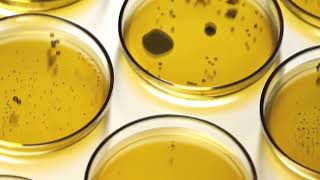

A key reason for Valley Fever’s spread – Climate change video
Online izle ve mp4 mp3 formatlarinda yukle

Videonun muddeti: 2:30
A key reason for Valley Fever’s spread – Climate change videosu mp4 ve mp3 yuklemek ucun hazirdir
Diqqet! Siz Mp4 yukle ve ya Mp3 yukle duymesine basdiqdan sonra eger sistem sizi reklam sehifesine atarsa o zaman derhal geri qayidib emeliyyati tekrar edin ve faylin yuklemek ucun hazir olmasini gozleyin
Videodan Mp4 Yukle
Videodan Mp3 Yukle-1
Videodan Mp3 Yukle-2
Oxshar Axtarishlar
 A key reason for Valley Fever’s spread – Climate change
A key reason for Valley Fever’s spread – Climate change Valley fever cases on the rise and may worsen due to climate change
Valley fever cases on the rise and may worsen due to climate change A deadly fungus is creeping toward Canada because of climate change
A deadly fungus is creeping toward Canada because of climate change Valley fever could spread from Southwest, driven by climate change, researchers warn
Valley fever could spread from Southwest, driven by climate change, researchers warn Valley fever, aka coccidioidomycosis, may be on the rise #shorts
Valley fever, aka coccidioidomycosis, may be on the rise #shorts "The role of climate change, wildfire, and rodents in the emergence of Valley fever in California"
"The role of climate change, wildfire, and rodents in the emergence of Valley fever in California" Climate Change Increases Range of Deadly Fungus
Climate Change Increases Range of Deadly Fungus Valley Fever, Causes, Signs and Symptoms, Diagnosis and Treatment.
Valley Fever, Causes, Signs and Symptoms, Diagnosis and Treatment. Valley Fever Rising! Incidence and Geographic Expansion
Valley Fever Rising! Incidence and Geographic Expansion
Video Mp4 Mp3Azwap.Biz
Azwap.Biz 2021-2023

A key reason for Valley Fever’s spread – Climate change
A key reason for Valley Fever’s spread – Climate change Valley fever cases on the rise and may worsen due to climate change
Valley fever cases on the rise and may worsen due to climate change A deadly fungus is creeping toward Canada because of climate change
A deadly fungus is creeping toward Canada because of climate change Valley fever could spread from Southwest, driven by climate change, researchers warn
Valley fever could spread from Southwest, driven by climate change, researchers warn Valley fever, aka coccidioidomycosis, may be on the rise #shorts
Valley fever, aka coccidioidomycosis, may be on the rise #shorts "The role of climate change, wildfire, and rodents in the emergence of Valley fever in California"
"The role of climate change, wildfire, and rodents in the emergence of Valley fever in California" Climate Change Increases Range of Deadly Fungus
Climate Change Increases Range of Deadly Fungus Valley Fever, Causes, Signs and Symptoms, Diagnosis and Treatment.
Valley Fever, Causes, Signs and Symptoms, Diagnosis and Treatment. Valley Fever Rising! Incidence and Geographic Expansion
Valley Fever Rising! Incidence and Geographic Expansion